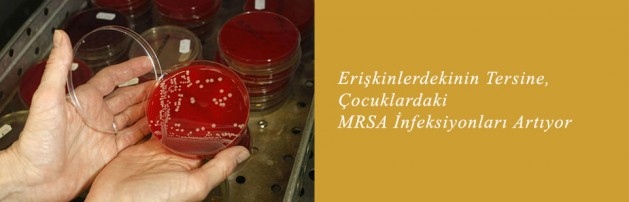

‘Superbug’ MRSA Infections Aren’t Dropping in Children: CDC
While overall rates still low for kids, study finds infants and black children face higher risk
By Serena Gordon
HealthDay Reporter
MONDAY, Sept. 23 (HealthDay News) — Although rates of infection with methicillin-resistant staphylococcus aureus (MRSA) are declining among American adults, the rates among children remain largely unchanged, a new government study finds.
In addition, MRSA disproportionately affects infants less than 3 months old and black children, according to the report from the U.S. Centers for Disease Control and Prevention, published online Sept. 23 and in the October print issue of Pediatrics.
MRSA is considered a “superbug” because it’s resistant to nearly all treatments, including the powerful antibiotic methicillin. The most recent figures from the CDC, reported in the Sept. 16 issue of JAMA Internal Medicine, found that 30,000 fewer MRSA infections occurred in 2011 compared to 2005.
Fortunately, rates in children are much lower than what has been reported in adults, according to the latest study’s lead author, Dr. Martha Iwamoto, a medical epidemiologist with the CDC. However, the number of cases in children didn’t decline significantly from 2005 to 2010.
The one bright spot in the latest findings was in infants under 90 days old. “We found that the numbers of invasive MRSA infections among young infants are going down,” Iwamoto said.
However, the incidence of infections in babies younger than 3 months was still significantly higher than in other children.
Rates of infections in black children were more than four times higher than in children of other races.
“We are making some progress in reducing the number of invasive MRSA infections in young infants in hospitals. However, more needs to be done, especially for children developing invasive MRSA outside of hospitals,” she said.
MRSA can cause a variety of illnesses from skin infections to a life-threatening blood infection. These types of infections were initially prominent in hospital settings, but even as prevention measures have reduced the number of infections within hospitals, community-based infections have increased.
To better identify how this super bug is affecting infants and children, Iwamoto and her colleagues reviewed reports of MRSA infections across the United States from 2005 to 2010.
They found a total of 876 pediatrics cases, 39 percent of them in infants, according to the study.
A little more than one-third of the cases were hospital-onset infections, while 42 percent were community-associated infections, which can occur through skin-to-skin contact in schools or daycare centers. The remaining 23 percent were health-care associated community-onset infections.
The incidence of community-acquired infections rose by 10 percent during the study time period.
Iwamoto said that if rates are to drop for older infants, “we need to focus on prevention of MRSA infections outside of hospitals.”
She said that while this study confirmed a racial disparity in MRSA infections, it’s not clear why that disparity exists. The presence of underlying disease might increase the susceptibility to infection, or socioeconomic factors, such as household crowding, might play a role too, she said. Additional studies need to be done to understand why this disparity exists so that something can be done to address it, she said.
An outside expert said the new study is helpful for those working to control MRSA.
“Continuing epidemiology surveillance like this is a way to get a sense of what’s going on,” said Dr. Kenneth Bromberg, director of the Vaccine Research Center and chair of pediatrics at the Brooklyn Hospital Center in New York City.
While the researchers are figuring out why infections continue to be high in babies and black children, there’s an easy way everyone can help stop the spread of infections, he said.
“The most effective means for preventing MRSA and other infectious diseases is normal hand hygiene using plain old soap,” Bromberg said. “Sing ‘Happy Birthday’ two times slowly while you’re washing your hands, and you’ve done it right. Hand washing is key in and out of the hospital.”